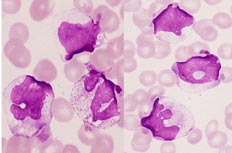
肝腫大

病因及病理
 肝腫大
肝腫大各種病原微生物性中毒性肝炎時,因炎症而有血管充血、組織水腫炎性細胞浸潤和其他炎性物質的滲出,或因肝細胞變性J脹,或因肝臟網狀內皮系統受刺激而大量增生造成肝腫大各種感染中以病毒性肝炎為常見。
(二)淤血
在充血性心力衰竭*心包填塞縮窄性心包炎、心包積液及肝靜脈回流受阻時,肝臟因充血而腫大外觀發紫,邊緣鈍。
(三)膽汁淤積
在原發性膽汁性肝硬化胰頭癌、肝內外膽道梗阻時,導致膽汁淤積造成肝腫大。
(四)中毒
某些藥物和肝毒素各種全身性感染時,病原體除可直接侵犯肝臟外,還可通過毒血症高熱、營養不良、缺氧等因素引起中毒性肝炎使肝細胞壞死,產生微囊型脂肪沉著,肝炎樣損傷肝纖維化,肝靜脈阻塞,毛細膽管淤膽等造成肝腫大。
肝腫大
肝腫大(五)代謝異常
脂肪肝肝澱粉樣變性等病時,脂肪、糖原類脂質、澱粉樣物質、銅或鐵質沉積在肝臟使之腫大。
(六)腫瘤和襄腫
(七)其他
診斷
病史往往能提供肝臟病的診斷線索要注意了解有否傳染病的接觸史,接受血液製品史,旅居流行地區史此有助於傳染病與寄生蟲病的診斷。藥物或毒物接觸史,可引起中毒性肝腫大肝硬化患者既往常有肝炎、黃疽、慢性酒精中毒等病史伴隨肝區疼痛者多見於肝內炎症、急性肝淤血、肝內占位性病變多為鈍痛性,但肝癌的疼痛可相當劇烈。伴有發熱常提示肝炎肝膿腫、膽道感染、肝癌或其他急性傳染病血液病、結締組織疾病等。病毒性或藥物性肝炎伴有納差。(一)病變範圍
1、瀰漫性腫大由於普遍性肝臟病變所致,見於各種肝炎J肪肝、肝澱粉樣變性肝瘀血、肝硬化、肝細胞癌轉移癌、膽管細胞癌。
2、局限性腫大由於肝內占位性病變所致,見於肝膿腫、肝囊腫肝腫瘤、肝包蟲等。
(二)肝的硬度
正常人體質瘦弱者可觸及肝邊緣且質軟肝臟中等硬見於肝炎、肝膿腫、血吸蟲病脂肪肝、瘧疾等。肝臟質地堅硬見於肝硬化、晚期血吸蟲病、淤血性肝硬化惡性腫瘤、白血病、肝澱粉樣變性梅毒肝等。
(三)肝的邊緣和表面
慢性肝炎淤血肝的邊緣較鈍,表面尚平滑,肝硬化的邊緣銳利表面呈結節狀。
(四)壓痛
急性肝炎急性肝淤血、急性膽管炎或膽絞痛發作時壓痛明顯,細菌性或阿米巴肝臟腫時壓痛更為劇烈主要為局限性壓痛,肝癌常無明顯的壓痛,慢性肝炎時壓痛較輕肝硬化*肪肝、肝澱粉樣變性與梅毒肝一般無壓痛。
(五)黃疽
器械檢查
 肝腫大
肝腫大超聲在肝膽疾病的診斷上可用於測量肝脾及膽囊位置大小、形態以及觀察肝靜脈*靜脈及其分支的變化;確定肝膽疾病的性質、部位和範圍證實臨床印象診斷和解決特殊問題;可在超聲探查的指引下進行經皮經肝穿刺膽道造影和引流,肝穿刺活體組織檢查;對已確診的肝膽疾病進行治療隨診觀察;進一步驗證核素檢查的結果,確定病變性質和深度肝膽疾病與周鄰臟器的關係。B超檢查對肝內占位性病變的診斷意義較大,直徑超過Icm的占位性病變可以被檢出。
(二)X線檢查
1、胸透可確定右隔的位置、形狀及運動。
2、胃腸鋇餐能發現食管靜脈曲張,並且對發現胰頭癌或壺腹癌所引起的膽道梗阻有助。
3、膽囊或膽管造影對膽囊病變或膽道梗阻有診斷價值,但不適於黃疸患者,此時須做經皮經肝穿刺膽管造影術以明確有無結石或腫瘤性梗阻其對膽管病變影像的清晰度較內鏡逆行胰膽管造影術為好但凝血酶原時間明顯延長時禁忌。十二指腸纖維內鏡進行逆行膽管造影的效果和經皮穿刺者相似。
(三)CT與MRI
對肝硬化脂肪肝、肝腺瘤的診斷,MRI不如CT但對肝囊腫、肝血管瘤的診斷MRI優於CT。
(四)放射性核素掃描
 肝腫大
肝腫大(五)腹腔鏡檢查
對各種肝病的診斷與鑑別診斷有一定的幫助用於確診肝炎、肝炎病期、肝炎並發症;肝硬化的原因性質、程度;腫瘤的性質、部位程度;決定是否須剖腹探查,以及腫瘤能否切除;對鑑別肝外梗阻和肝內膽汁淤積亦有一定幫助。
(六)肝血管造影
有牌門靜脈造影肝靜脈造影、肝動脈造影、經臍靜脈門脈造影等方法脾門靜脈造影可了解門靜脈系統梗阻情況和測定門靜脈壓力。肝靜脈造影可了解肝靜脈的梗阻情況。肝動脈造影對肝臟腫瘤手術切除的可能性和切除範圍的估計有一定的幫助MRI可取代部分侵人性的血管造影檢查。
(七)肝血流圖
是一種無損傷性檢查肝臟和血管功能的一種方法通過測定肝區組織對高頻電流的阻抗變化,以反映肝臟的血液循環狀態,並藉以判斷肝臟功能及病理變化診斷和了解疾病的演變。預後和轉歸,肝血流圖對病因雖無特異性但對肝臟病變程度的反映具有意義,對慢性肝炎、肝硬化早期門脈高壓J心源性肝淤血的判斷、肝癌的診斷和定位都有一定的價值。
(八)肝穿刺活體組織檢查
其適應證是原因未明的肝腫大對明確診斷移斷療效和預後,了解各種肝病的演變過程,提供了可靠的科學依據在重度黃疽、腹水或凝血障礙時則為禁忌。
病毒性感染
 肝腫大
肝腫大(1)急性黃疽型:可分為三期d①黃疽前期一般2-16d。②黃疽期,約在發病後一周肝脾腫大黃疽在互一2周內達高峰,隨即逐漸減輕,一般2-4周內消退兒童尤速。③恢復期,黃疽漸退肝腫痛及其他症狀也減輕,食慾正常,但仍有乏力及輕度肝區痛此期約一個月。兒童較輕,成人較重黃疽可持續約3-4周。
(2)急性無黃疽型肝炎:除無黃疽外發病與黃疽型類似,但一般較輕,病程較短若未能及時適當休息,病程可能延長,但並不轉為慢性。
(3)暴髮型肝炎:少見起病同急性肝炎,但病勢發展快,病程不超過2-3周病死率高,起病時可先出現精神症狀或性格改變,易誤診應注意有無高熱、肝濁音界縮小,輕度腹水並每日連續觀察血清膽紅素及轉氨酶。多死於肝功能衰竭、凝血機制受損胃腸出血、腦水腫、腦疝等。
2、乙型病毒性肝炎乙型病毒性肝炎潛伏期較長6周至6個月,其發病和機體免疫應答及免疫調節功能紊亂有關。血清GPT可增高HBsAg陽性、抗一HBcIgM抗體陽性、e抗原陽性者有傳染性凡e抗原陽性者DNA多聚酶亦呈陽性,血清中DNA聚合酶陽性是病毒活的一個指標,持續e抗原陽性的慢性HHV感染者的肝臟內基本上都有慢性活動性炎症HB-SAg滴度由高到低,消失後抗HBS陽性;或急性期抗一HBC-IGM滴度高水平,而抗HBC-IGG陰性或低水平可診為急性乙型病毒性肝炎臨床符合慢性肝炎,且有HBV感染的一種以上陽性標誌為慢性乙型病毒性肝炎。無任何臨床症狀和體徵肝功能正常,而HBSAG血症持續陽性6個月以上者為慢性HBSAG攜帶者。
 肝腫大
肝腫大4、丁型病毒性肝炎丁型病毒性肝炎的傳播途徑與乙型病毒性肝炎相同,可經輸血、血制品注射、針刺、密切接觸和圍產期傳播我國慢性活動性肝炎中合併了型毒性肝炎者較多,其診斷依據為:①血清抗一HD-IGM、或抗HD或HDA陽性。②血清中HDV-RNA陽性。③肝組織HDAG或HDV-RNA陽性臨床表現可分為HBV/HDV的聯合感染;HBV和HDV的重疊感染。
(1)聯合感染:常見有兩種情況一種HBV/HDV聯合感染病程呈良性自限性經過,臨床表現類似單純HBV急性感染,有時可見穀雨氨基轉移酶雙峰第一峰為HBV所致,第二峰為HDV所致。另一種HBV/HDV聯合感染表現為重型或暴髮型肝炎。
(2)重疊感染:臨床表現也分為兩種一種為HBSAG無症狀攜帶者發生急性肝炎時,表現為典型的HBSAG陽性肝炎,病情較單純HBV感染嚴重應注意丁型病毒性肝炎及丙型病毒性肝炎的重疊感染,HBSAG陽性的暴發性肝炎中有不少是由於HDV重疊感染。一種為HBV所致慢性肝炎患者重疊感染HDV可使HBV的病變加重並促進向慢性活動性及肝硬化發展。當乙型遷延性肝炎迅速發展為慢性活動性時,也應考慮是否發生HDV重疊感染。
5、成型病毒性肝炎戊型病毒性肝炎流行範圍很廣,某些地區成型病毒性肝炎可占臨床病毒性肝炎的50%,一年四季均可流行但以秋冬季節多見,常在雨後或洪水後,以水源污染引起流行在發病前l-4d糞便中即可檢出HEV發病後2周內仍可排毒。起病時約半數患者有發熱、關節痛黃疽、膽汁淤積及陶土樣便較甲型病毒性肝炎為多見,症狀一般較甲型病毒性肝炎為重戊型病毒性肝炎和甲型病毒性肝炎雖同為經口傳染的RNA病毒,臨床上主要不同之處在於甲型病毒性肝炎的感染率高而發病率低,多侵犯幼兒兒童戊型病毒性肝炎感染後發病率高,多侵犯成人以30-40歲最多,病死率約1%-2%為甲型病毒性肝炎的10倍,孕婦中戊型病毒性肝炎病死率可達I20%-30%,尤以妊娠中晚期為重,多為暴發I型。
6、傳染性單核細胞增多症本病常有肝腫大和肝功能異常,但發熱比肝炎高,持續時間亦較久常有咽部疼痛、充血和內分泌物,頸及其他部位的淋巴結常腫大脾腫大及觸痛較明顯。白細胞計數正常或增多,單核細胞在0.50以上異常淋巴細胞在0.10以上,嗜異性凝集試驗陽性,抗EB病毒抗體效價有4倍以上增長或特異IGM型抗體陽性,肝活檢可見瀰漫性單核細胞浸潤及局灶性肝壞死。
7、巨細胞病毒感染正常成人受染後可出現傳染性單核細胞增多症樣的症狀、體徵和典型血象,但嗜異性凝集試驗陰性,肝臟腫痛及肝功異常較輕,肝活組織檢查可見炎性浸潤及輕度肝細胞壞死或呈小型肉芽腫及巨細胞,而在肝內找出巨細胞包涵體的機會不多。免疫抑制患者受染後可無症狀或有多數臟器受累,如肝炎、肺炎關節炎及其他多處的病變,可有發熱、白細胞減少淋巴細胞增多、異常淋巴細胞增多、肝脾腫大肌痛及關節痛。確診主要依靠從血液、尿液痰或糞便分離病毒,新鮮尿離心沉澱或口咽部分泌物塗片染色鏡檢包涵體,或雙份血清做補體結合試驗或中和試驗抗CMV效價遞升而抗EBV陰性熱為立克次體性感染,可有乏力、納差噁心J吐,大多數伴有右上腹痛及肝腫大,壓痛可不顯著;部分患者伴有脾腫大及黃疽病程中可有絮濁反應陽性及血清氨基轉移酶。鹼性磷酸酶活力上升,常類似病毒性肝炎但以下各點有助鑑別:①起病寒戰、發熱顯著,熱度較高持續1-3周,頭痛、腰背及髒腸肌痛顯著;②部分患者可伴發非典型肺炎;③有牛羊等畜類接觸史,尤其是疫區牧場、屠宰場肉類加工廠、製革廠等工作人員較易得病;④反相間接血凝及酶聯免疫吸附測定抗原有助早期診斷。
瘀血性
 肝腫大
肝腫大2、慢性縮窄性心包炎既往常有結核性心包炎、化膿性心包炎、病毒性心包炎或心臟外傷史有較明顯的頸靜脈充盈,靜脈壓升高,有奇脈肝頸靜脈反流徵陽性一心臟正常或稍大,心臟搏動明顯減弱,心音遙遠有心包叩擊音。X線檢查示肺門血管影清晰,心包正常輪廓改變或心包鈣化影肝臟明顯腫大,無痛,牌可輕度腫大肝功正常或輕度異常。
3、柏一查綜合徵20-45歲的男性發病率高。由於引起肝靜脈或下腔靜脈阻塞的病因、位置範圍、程度、發病的急緩及病程長短不同臨床表現亦有差異。急性期以迅速出現的肝區疼痛,進行性肝腫大迅速增長的腹水為特徵,腹壁靜脈擴張,伴有不同程度的肝臟功能損害重者呈現休克或肝功能衰竭迅速死亡。慢性期除部分患者由急性期轉來外,多數呈隱襲性起病症狀和體徵緩慢出現,病期長者有脾腫大和食管靜脈曲張,合併下腔靜脈阻塞者胸。腹壁靜脈怒張十分明顯,血流方向自下而上雙側下肢水腫,小腿皮膚有棕褐色色素斑點,重者下肢靜脈曲張甚至足踝部發生營養性潰瘍,雙側下肢靜脈壓升高。肝功能僅有輕度損害磺澳酞鈉試驗輕度滯留,鹼性磷酸酶升高。B超檢查可以顯示下腔靜脈內徑大小判斷有無狹窄或阻塞,以及阻塞的位置和範圍,肝脾的大小和形態,有無腹水等。核素肝掃描肝臟增大形態失常,示蹤劑聚集於充血肥大的肝尾葉,呈“中央濃集”現象肝右葉示蹤劑呈稀疏狀分布或明顯減少。血管造影可以確定阻塞的部位。性質範圍和程度,不僅提供重要的診斷證據,而且為臨床分型和選擇正確的手術方法提供重要依據是不可缺少的檢查。
膽汁淤滯性
1、肝內膽汁淤積
包括肝門部及肝內膽管梗阻性病變及主要由於功能性障礙所致者。常見於中、青年人有肝炎或肝毒藥物接觸史,發病時可有病癢感,低熱黃疽發生快且比較輕容易變,早期肝區疼痛,肝臟稍腫大無壓痛,間歇性白陶土色便。血清膽紅素為結合型十二指腸引流間歇性無膽汁,血清膽固醇常上升,並與膽固醇脂平行血清ALP上升,SGOT、SGPT<100血清B1球蛋白增加,凝血酶原時間延長S超及CT檢查示肝膽管無擴張,膽管造影經皮肝膽管造影術不能顯示內鏡逆行胰膽管造影術正常。
 肝腫大
肝腫大(1)膽總管結石:有膽道蛔蟲病及反覆發作史陣發性上腹或右上腹絞痛,發熱、寒戰黃疽呈波動性,膽囊不一定能觸及,肝腫大不明顯間歇性白陶土色便。白細胞總數及中性粒細胞升高,尿膽素不定血清氨基轉移酶增高及下降迅速,血清鹼性磷酸酶升高,十二指腸引流液有膽紅素鈣結晶或大量膿細胞X線檢查可見膽管擴張及結石陰影。B超檢查顯示強回聲後有聲影,結石可隨體位變化而移動CT檢查示總膽管橫斷面呈境界清楚圓形或卵圓形低密度影,自上而下逐漸變小,總膽管輕度擴張。
(2)膽管癌:臨床表現以阻塞性黃值為最突出黃疽可持續上升亦可暫時減輕,伴有上腹疼痛,胃腸道症狀體重減輕,身體瘦弱,乏力呈惡病質,肝腫大,有時可觸及腫大的膽囊可有腹水,具體表現視癌腫的部位與病程的早晚而不同。血尿、糞分別檢查膽紅素、尿(糞)膽原尿(糞)膽素及血清鹼性磷酸酶都增高。十二腸指引流液中膽汁含血或膽汁量極少,引流的膽汁液中找到癌細胞可明確診斷B超檢查示膽囊腫大,明顯積液,但無結石陰影胰膽管造影,膽管某段可顯示狹窄、充盈缺損經皮肝膽道造影可顯示肝內膽管擴張,肝外膽管某一部分充盈缺損,管腔狹窄變毛糙等。
(3)胰頭癌:上腹部或臍周疼痛向左腰背放射,黃疸進行性加重,皮膚癌癢少見肝、膽腫大,常有胰腺炎十二指腸引流液可見癌細胞或紅細胞。十二指腸鋇劑造影顯示十二指腸環擴大。B超檢查示膽囊腫大總膽管擴張,胰頭實質性包塊。內鏡逆行胰膽管造影術顯示膽管中斷狹窄、移位、腺泡充盈缺損。
(4)壺腹癌:可有慢性膽囊炎膽石症史,50歲以上男性多見。上腹深部持續疼痛或隱痛向背部放射,黃疽進行性加重,可有波動性常見皮膚癌癢,肝腫大、質硬無觸痛中上腹可觸及包塊,且可伴有消化道出血、膽管炎胰腺炎,轉移較晚,糞便呈進行性白陶土色白細胞數正常,便隱血試驗陽性、尿膽素陽性氨基轉移酶正常,鹼性磷酸酶升高。十二指腸引流可見癌細胞及出血十二指腸造影降段有倒“3”字形。B超檢查示梗阻以上膽管擴張,不均勻低回聲內鏡逆行胰膽管造影術顯示乳頭區腫瘤陰影。CT檢查顯示總膽管和胰管擴張,擴張的膽管保持圓形。
預防保健
1.飲食方面應提供足夠的營養,食物要多樣化,供給含胺基酸的高價蛋白質、多種維生素、低脂肪、少渣飲食,要防止粗糙多纖維食物損傷食道靜脈,引起大出血。
2.血氨偏高或肝功能極差者,應限制蛋白質攝入,以免發生肝昏迷。出現腹水者應進低鹽或無鹽飲食。3.每日測量腹圍和測定尿量,腹部肥胖可是自我鑑別脂肪肝的一大方法。
4.注意出血、紫癜、發熱、精神神經症狀的改變,並及時和醫生取得聯繫。
5.補硒養肝,補硒能讓肝臟中谷胱甘肽過氧化物酶的活性達到正常水平,對養肝護肝起到良好作用,硒麥芽粉、五味子餵成分的養肝片,對養肝護肝起到良好作用調節免疫,對養肝、護肝有良好作用。
病變範圍
1.瀰漫性腫大由於普遍性肝臟病變所致,見於各種肝炎J肪肝、肝澱粉樣變性肝瘀血、肝硬化、肝細胞癌轉移癌、膽管細胞癌。
2.局限性腫大由於肝內占位性病變所致,見於肝膿腫、肝囊腫肝腫瘤、肝包蟲等。
肝的硬度
正常人體質瘦弱者可觸及肝邊緣且質軟肝臟中等硬見於肝炎、肝膿腫、血吸蟲病脂肪肝、瘧疾等。肝臟質地堅硬見於肝硬化、晚期血吸蟲病、淤血性肝硬化惡性腫瘤、白血病、肝澱粉樣變性梅毒肝等。
肝的邊緣和表面
慢性肝炎淤血肝的邊緣較鈍,表面尚平滑,肝硬化的邊緣銳利表面呈結節狀。
壓痛
急性肝炎急性肝淤血、急性膽管炎或膽絞痛發作時壓痛明顯,細菌性或阿米巴肝臟腫時壓痛更為劇烈主要為局限性壓痛,肝癌常無明顯的壓痛,慢性肝炎時壓痛較輕肝硬化、肪肝、肝澱粉樣變性與梅毒肝一般無壓痛。
黃疽
病毒性肝炎膽汁性肝硬化、肝外膽道梗阻多見。
肝臟疾病匯總
病毒性肝炎 | 肝膿腫 | 肝結核 | 肝吸蟲病 | 阿米巴肝膿腫 | 良惡性腫瘤 | 肝囊腫 | 肝膿腫 | | 肝包蟲病肝血管瘤 | 肝內膽管結石 | 脂肪肝 | 中毒性肝病 | 自身免疫性肝病 | 黃疸 | Gilbert綜合徵 | 多發性肝囊腫 | 肝海綿狀血管瘤 | 酒精性肝硬化 | 原發性膽汁性肝硬化 | 肝癌 | B肝 | A肝 | C肝 | 膽汁淤積 | 肝腫大 | 門脈高壓症 | 腹水 | 肝性腦病 | 肝功能衰竭| 脾大| 膽管結石
消化系統疾病
| 消化系統疾病一直是影響人類生存質量的主要疾病,特別是消化系統腫瘤更是嚴重威脅人類健康。醫學統計數據表明,屬於消化系統腫瘤的肝癌和胃癌長年來一直位於我國腫瘤發病率的第二位和第三位。 | |||
| 胃炎 急性胃炎 急性胃腸炎 胃潰瘍 慢性萎縮性胃炎 慢性胃炎 慢性淺表性胃炎 消化性潰瘍 胃腸道脹氣 腸上皮化生 胃癌 胃痛 急性胃擴張 胃柿石症 胃黏膜脫垂症 胃下垂 胃泌素瘤 傾倒綜合徵 胃扭轉 小腸腫瘤 阿狄森氏病 | 大腸癌 直腸癌 肛門直腸損傷 結腸直腸腺瘤 克隆氏病 腸中風 急性腸炎 慢性腸炎 急性腸梗阻 急性腸胃炎 偽膜性腸炎 放射性腸炎 直腸陰道瘺 腸結核 缺血性腸病 闌尾炎 急性闌尾炎 蛔蟲病 蟯蟲病 鉤蟲病 | 先天性肛門閉鎖 肛門瘺管 肛裂 肛門梳硬結 肛門濕疹 肛門直腸先天畸形 直腸脫垂 肛門瘙癢 大便失禁 肛管直腸癌 便秘 器質性便秘 功能性便秘 結腸性便秘 妊娠便秘 產褥期便秘 小兒便秘 急性細菌性痢疾 小兒便血 胃原性腹瀉 | 感染性腹瀉 食物中毒 腺病毒胃腸炎 慢性肝炎 小兒肝炎 藥物性肝炎 酒精性肝炎 肝昏迷 肝功能衰竭 肝細胞凋亡 肝腫大 黃疸 老年肝硬化 肝纖維化 門靜脈高壓症 肝腎綜合徵 肝吸蟲病 肝功能檢查 肝穿刺 肝移植術 |

